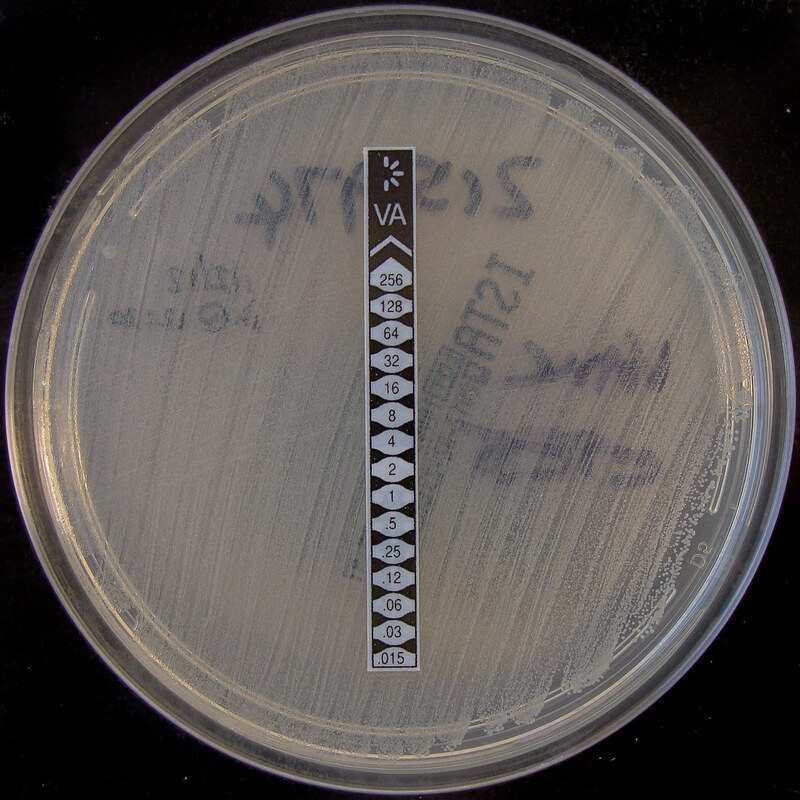
Отмена мер предосторожности при контактах с MRSA, VRE не привела к увеличению числа внутрибольничных инфекций

Отмена мер предосторожности при контактах с MRSA и ванкомицин-резистентными Enterococcus (VRE) не привела к росту числа внутрибольничных инфекций (ВБИ) в системе больниц штата Пенсильвания, согласно результатам исследования.
"Хотя меры предосторожности при контакте с MRSA и VRE широко распространены в больницах США, некоторые больницы пересматривают их использование, учитывая потенциальный вред для пациентов, такой как уменьшение числа посещений медицинских работников, потенциальное повышение уровня тревожности и депрессии, а также неинфекционные неблагоприятные события", - сообщила Элиз М. Мартин, помощник медицинского директора по профилактике инфекций и госпитальной эпидемиологии и врач отделения инфекционных заболеваний больницы Пресвитерианского медицинского центра Питтсбургского университета (UPMC).
По словам Мартин, в нескольких работах было показано, что контактные меры предосторожности в отношении MRSA и VRE могут быть отменены при хороших мерах горизонтальной профилактики инфекций без увеличения числа инфекций, связанных с оказанием медицинской помощи (ИСМП), однако данные о том, безопасно ли это делать в других учреждениях, таких как муниципальные больницы, ограничены. Данные о том, какие методы профилактики инфекций необходимы для достижения успеха, также ограничены.
В рамках исследования Мартин и ее коллеги отменили контактные меры предосторожности в отношении MRSA и VRE в 12 больницах системы здравоохранения UPMC и продолжили их в трех других. Они собрали и проанализировали показатели заболеваемости ВБИ MRSA и VRE за 12 месяцев до и после преобразований.
В целом, исследование показало, что совокупные показатели ВБИ в больницах вмешательства до и после прекращения применения контактных мер предосторожности составили 0,14 и 0,15 ВБИ MRSA на 1000 пациенто-дней (P = .74), 0,05 и 0,05 ВБИ VRE на 1000 пациенто-дней (P = .96) и 0,04 и 0,04 случаев лабораторного выявления MRSA на 100 госпитализаций (P = .57), без статистически значимых изменений показателей между больницами, которые прекратили или продолжили применение мер предосторожности.
"Вполне возможно безопасно отменить меры предосторожности при контакте с MRSA и VRE в различных больницах без возникновения вспышек инфекций. Все наши успешные больницы имели низкие исходные показатели инфицирования MRSA и VRE, а также высокий уровень соблюдения гигиены рук", - отметила Мартин. "Если ваша больница заинтересована в отмене мер предосторожности при контакте с MRSA и VRE, убедитесь, что показатели MRSA и VRE низкие, а соблюдение правил гигиены рук очень высокое, прежде чем рассматривать вопрос об отмене мер предосторожности при контактах".